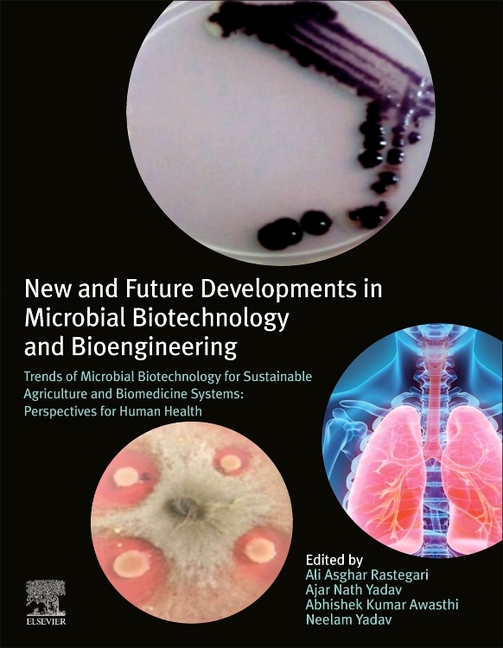
New and Future Developments in Microbial Biotechnology and

Microbiology in 2025: A Glimpse into the Future of Microbial Research
Related Articles: Microbiology in 2025: A Glimpse into the Future of Microbial Research
Introduction
In this auspicious occasion, we are delighted to delve into the intriguing topic related to Microbiology in 2025: A Glimpse into the Future of Microbial Research. Let’s weave interesting information and offer fresh perspectives to the readers.
Table of Content
Microbiology in 2025: A Glimpse into the Future of Microbial Research

The field of microbiology is undergoing a rapid transformation, driven by advancements in technology, a growing understanding of microbial diversity, and a heightened awareness of the crucial role microorganisms play in our world. As we approach 2025, certain trends are poised to shape the future of microbial research, impacting everything from healthcare and agriculture to environmental sustainability.
Understanding trends microbiology impact factor 2025 is essential for researchers, scientists, and policymakers alike. This article delves into the key trends shaping the field, examining their potential impact and exploring the factors that will drive their evolution.
1. The Rise of Precision Microbiology
Precision medicine, a personalized approach to healthcare, is rapidly gaining traction. Similarly, precision microbiology aims to tailor treatments and interventions based on the unique microbial profiles of individuals. This trend leverages the power of high-throughput sequencing and bioinformatics to analyze the complex communities of microbes inhabiting our bodies, known as the microbiome.
Benefits of Precision Microbiology:
- Personalized Therapies: Understanding the specific microbial composition of a patient allows for targeted therapies, potentially leading to more effective treatments for conditions like inflammatory bowel disease, obesity, and even cancer.
- Probiotics and Prebiotics: Precision microbiology provides insights into the optimal strains of probiotics and prebiotics for individual needs, enhancing their effectiveness in promoting gut health and overall well-being.
- Early Disease Detection: Microbial profiles can serve as early indicators of disease, enabling proactive interventions and potentially preventing the onset of chronic conditions.
2. The Microbial World: A Frontier of Drug Discovery
Microorganisms have long been a source of life-saving antibiotics, but the rise of antibiotic resistance is a pressing global health concern. trends microbiology impact factor 2025 will see a renewed focus on discovering novel antimicrobial agents from diverse microbial sources.
Emerging Trends in Antimicrobial Discovery:
- Phage Therapy: Bacteriophages, viruses that specifically target bacteria, are gaining recognition as a potential alternative to antibiotics. Research is exploring the efficacy of phage therapy in treating infections resistant to conventional antibiotics.
- Synthetic Biology: Utilizing synthetic biology tools, scientists are engineering microbes to produce novel antibiotics, potentially overcoming the limitations of traditional approaches.
- Exploring Underexplored Microbial Habitats: Scientists are venturing into extreme environments like deep-sea vents and volcanic soils to discover novel microbes with potential therapeutic properties.
3. Harnessing the Power of Microbes for Environmental Sustainability
Microorganisms are not just agents of disease; they are also essential players in maintaining a healthy planet. trends microbiology impact factor 2025 will witness a significant shift towards harnessing the power of microbes for environmental remediation and sustainable practices.
Microbes as Environmental Solutions:
- Bioremediation: Microbes can break down pollutants and toxins, cleaning up contaminated soil and water. Bioremediation techniques are becoming increasingly sophisticated, offering environmentally friendly solutions to pollution problems.
- Biofuel Production: Microbes can be engineered to produce biofuels, reducing our reliance on fossil fuels and mitigating climate change.
- Sustainable Agriculture: Microbial communities in soil play a vital role in plant growth and nutrient cycling. Research is exploring ways to manipulate these communities to enhance crop yields and reduce the need for synthetic fertilizers.
4. The Microbiome: A Bridge Between Health and the Environment
The human microbiome, the collection of microbes inhabiting our bodies, is increasingly recognized as a key factor influencing our health. trends microbiology impact factor 2025 will see a growing focus on understanding the interconnectedness between the microbiome and the environment.
Exploring the Environmental Impact on the Microbiome:
- Climate Change and Microbiome: Climate change is impacting microbial communities in various ecosystems, potentially altering human health and disease patterns. Research is investigating the long-term effects of climate change on the microbiome.
- Antimicrobial Resistance and the Environment: Antibiotic resistance is a global threat, and environmental contamination with antibiotic residues plays a significant role in its spread. Understanding the role of the environment in the emergence of antibiotic resistance is crucial for developing effective solutions.
- The Microbiome and Human Health: Exposure to diverse microbial communities in the environment, particularly in early childhood, can contribute to a healthy immune system and reduce the risk of allergies and autoimmune diseases.
5. Artificial Intelligence and Machine Learning: Revolutionizing Microbial Research
The vast amount of data generated in microbiology research presents a significant challenge for analysis and interpretation. trends microbiology impact factor 2025 will see the widespread adoption of artificial intelligence (AI) and machine learning (ML) tools to tackle this challenge.
AI and ML in Microbiology:
- Data Analysis and Interpretation: AI and ML algorithms can analyze vast datasets, identifying patterns and trends that might be missed by human researchers. This allows for faster and more accurate interpretation of experimental data.
- Predictive Modeling: AI and ML can be used to develop predictive models for microbial behavior, allowing scientists to anticipate how microbes will respond to different conditions.
- Drug Discovery and Development: AI and ML are being used to accelerate the process of drug discovery, identifying potential drug targets and designing novel antimicrobial agents.
6. The Ethical Dimensions of Microbiome Research
As our understanding of the microbiome deepens, ethical considerations become increasingly important. trends microbiology impact factor 2025 will see a growing emphasis on responsible microbiome research and the ethical implications of manipulating microbial communities.
Ethical Considerations in Microbiome Research:
- Informed Consent and Data Privacy: Collecting and analyzing microbiome data raises ethical concerns about informed consent and the privacy of individuals’ genetic information.
- Equity and Access: Ensuring equitable access to microbiome-based interventions is crucial to avoid exacerbating existing health disparities.
- Environmental Impact: Manipulating microbial communities in the environment requires careful consideration of potential unintended consequences.
7. Citizen Science and Open Data: Engaging the Public in Microbial Research
trends microbiology impact factor 2025 will see a growing trend towards citizen science and open data sharing in microbiology. This approach fosters collaboration and empowers the public to participate in scientific research.
Benefits of Citizen Science and Open Data:
- Increased Engagement: Citizen science projects allow individuals to contribute to research, increasing public awareness and understanding of microbiology.
- Data Collection and Analysis: Citizen science can contribute to data collection on a large scale, providing valuable insights into microbial diversity and distribution.
- Open Data Sharing: Making research data publicly available allows for greater collaboration and accelerates the pace of scientific discovery.
8. Microbiology Education: Fostering the Next Generation of Microbiologists
trends microbiology impact factor 2025 will see a renewed focus on microbiology education, attracting and training the next generation of scientists to address the challenges and opportunities in this rapidly evolving field.
Key Initiatives in Microbiology Education:
- Interdisciplinary Approaches: Integrating microbiology into other disciplines like medicine, environmental science, and agriculture will foster a broader understanding of the importance of microbes.
- STEM Education: Promoting STEM education from an early age will encourage young people to pursue careers in microbiology and related fields.
- Public Outreach: Increasing public awareness of the importance of microbes through engaging outreach programs will inspire the next generation of scientists.
Related Searches:
- Future of Microbiology
- Microbial Research Trends
- Impact Factor of Microbiology Journals
- Microbiology in Healthcare
- Microbiome and Human Health
- Environmental Microbiology
- Antimicrobial Resistance
- Biotechnology and Microbiology
FAQs:
Q: What is the trends microbiology impact factor 2025?
A: trends microbiology impact factor 2025 refers to the key trends shaping the field of microbiology in the coming years, impacting research, healthcare, and environmental sustainability.
Q: How will trends microbiology impact factor 2025 impact healthcare?
A: trends microbiology impact factor 2025 will see a significant shift towards precision medicine in microbiology, leading to personalized therapies, more effective probiotics, and earlier disease detection.
Q: What are the ethical considerations associated with trends microbiology impact factor 2025?
A: trends microbiology impact factor 2025 raises ethical concerns regarding informed consent, data privacy, equity in access to microbiome-based interventions, and the potential environmental impact of manipulating microbial communities.
Q: What is the role of citizen science in trends microbiology impact factor 2025?
A: Citizen science projects will play an increasingly important role in trends microbiology impact factor 2025, fostering public engagement, contributing to data collection, and promoting open data sharing.
Tips for Staying Ahead of trends microbiology impact factor 2025:
- Stay Informed: Follow microbiology journals, attend conferences, and engage with online resources to stay abreast of the latest research and developments.
- Embrace Interdisciplinarity: Seek out opportunities to collaborate with researchers in other fields, fostering a broader understanding of the role of microbes.
- Support Open Data: Advocate for open data sharing in microbiology research, enabling greater collaboration and accelerating scientific discovery.
- Engage in Citizen Science: Participate in citizen science projects to contribute to research and promote public awareness of microbiology.
Conclusion:
trends microbiology impact factor 2025 represents a pivotal moment in the field of microbiology. Advancements in technology, coupled with a growing appreciation for the vital role of microbes in our world, are driving innovation and shaping the future of microbial research. By embracing these trends, we can unlock the potential of microbes to address pressing global challenges in healthcare, agriculture, and environmental sustainability.

Closure
Thus, we hope this article has provided valuable insights into Microbiology in 2025: A Glimpse into the Future of Microbial Research. We thank you for taking the time to read this article. See you in our next article!